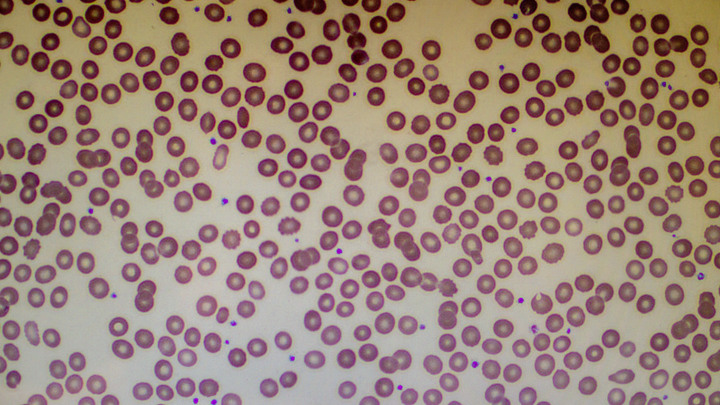

Группа Раком Фото

⚡ 👉🏻👉🏻👉🏻 ВСЯ ИНФОРМАЦИЯ ДОСТУПНА ЗДЕСЬ, КЛИКАЙ 👈🏻👈🏻👈🏻
Откровенные фото жен, сделанные мужьями (18+): dymontiger . . .
Слив голых домашних фото Рамазановой Раи (19 лет) без ретуши
Онколог назвал группы людей с высоким риском заболевания раком
Голый Воробьев Без Трусов | ((((Группа для тех,кто любит . . .
Жены порно онлайн на - Порно .ру .нет
26 безумных фотографий девушек, которые не должны были . . .
голые женщины 45 лет видео - Результаты поиска Yahoo
Домашнее порно онлайн на - Порно .ру .нет
зрелые тетки - Поиск в Google
Домашнее порно видео - Google Search
Жена Маковецкого Елена Фото
Фото 10 Лет Назад И Сейчас
Фото В Поле На Даче
В 2013 году я писал пост о доме в деревне, где провел детство и сейчас летом часто там бываю .
Рамазанова Рая - слив интимных домашних голых фото и видео девушки (18+) Очень сочная кискa, с отличными формами - Рая 🤤 . Нашел эту красавицу вконтакте (точнее она меня нашла 😍) Сразу понял что . . .
Всего специалист перечислил пять групп, которые, по его слова, болеют раком чаще остальных .
Фото голой елены воробей - Домашнее секс лесби фото Девочка и мальчик голые в бане рассказ - PDF - DocPlayer .ru Огромная срака раком голая фото ал на водонаева фото видео алексей воробьев голый
porn .ru .net › zheny
У нас на сайте отобрано самое сочное Жены порно в лучшем качестве, чтобы ты как зритель мог сполна насладиться отменной картинкой .
26 безумных фотографий девушек, которые не должны были попасть в интернет . (26 фото) Автор: Преподобный Стасян . 08 мая 2016 11:47 . Метки: Юмор девушки приколы фото . 1867568 . 26 . Зачастую случается так, что . . .
Голые зрелки . Сочные женщины в самом соку . Голые зрелки . Зрелая баба встала раком . Голая любовница не против секса . Старуха раздвинула ноги, а там голая манда . Женщина за 45 лет совсем голая . . .
porn .ru .net › domashnee
Домашнее порно видео . Смотреть видео Домашнее в хорошем качестве . Минет любительниц (лучшее из лучших) . Домашнее, Минет, Девушки, 1 ч . 58 мин . Домашний секс молодой (18 лет) пары . POV — от первого . . .
wap .google .com › search?q=зрелые+тетки&hl=ru&source=lnms&sa=X&ved=0ahUKEwiDnZeYh_XwAhUIgp4KHcczAXMQ_AUIBCgA
Зрелые тетки . 2018-05-21 . TXXX · Зрелые тетки · 7:54 . Горячие жопы, Кончи в жопу, Зрелые тетки, Мамка ебет молодых, Свингеры на . 2020-11-10 .
Домашнее порно снимают влюблённые парочки, жаждущие всеобщего внимания . Смотреть домашний секс видео, скачать порно бесплатно в качестве hd онлайн 365 дней . . .
Картинки Инстаграм Стулья Реклама
Алексин В Стране Вечных Каникул Картинки
Физическая Карта Полушарий Фото
Лада Веста Вид Сзади Фото
Фото На Памятник Ишим
Бесплатное Порно Фото Зрелые В Чулках
Прекрасная Природа Картинки
Красивые Гостиные В Частном Доме Фото
Полный Курс Фотографии
Фотография Алексея 2
Картинки Кавай Для Срисовки Легкие
Фото Голых Пар
Прописи С Картинками Для Детей 5 Лет
Скачать Приложение Для Анимации Фото
Фотография Любимого Сериал
Порно Фото Попы Частное
Невель Кухня Фото В Интерьере Отзывы
Найти Красивую Картинку Про Любовь
Бибиев Фото У Храма
Гостиная Фото Дизайн Со Шкафом
Вспашка Земли Фото
Простая Укладка На Средние Волосы Фото
Ногти Картинки Без Рисунков
Фото Шикарных Ножек
Картинки Темного Лорда Спайка Из Бравл
Коринн Клери Горячие Фото В Молодости
Картинка Телефона Пнг
Младенец Фото Со Спины
Живот С Мальчиком И Девочкой Разница Фото
Скачать Анимационные Картинки Для Презентаций
Комната Кати Адушкиной Фото
Фото Эндометриоза Матки Узи
Просмотр Фото И Видео Файлов
Прививка От Коронавируса Смешные Картинки
Фото Тока Ворлд
Русские Голые Тетки На Улице Частное Фото
Картинки Для Выжигания На День Рождения
Фото Кап Для Выравнивания Зубов
Фото Новой Версии Майнкрафта
Николь Нуриева С Мамой Фото
Самый Красивый Мотоцикл Фото
Сделать Фото 3х4 На Телефоне Приложение Айфон
Фото Подростка 14 Лет
Шеф Кухни Воронеж Каталог Цены Фото
Порно Фото Ретро 80 Года
Черниговка Приморский Край Фото
Спокойной Ночи Любимая Скучаю По Тебе Картинки
Как Сохранить Фото В Галерее
Волосы Назад Картинка
Комнатные Цветы В Гостиной Фото
Плетение Роза Фото
Шкода Суперб 2022 Фото Салона
Выпечка С Абрикосом Рецепты С Фото
Девушки Трусиков Под Юбкой Подборки Фото
Как Называется Фото Без Фона Для Фотошопа
Красивые Рамки Для Фотографий Купить
Найденное Тело Сергея Бодрова Фото
Создание Видеороликов Из Фотографий Приложение
Зрелые Любительские Эро Фото
Пьяный Разврат Фото
Обувь От Павла Воли Фото
Екатерина Кузнецова Фото Горячие Слив 18
Картинки На День Автомобилиста Мужчине
Читать Кошкин Дом Маршака С Картинками
Продам Квартиру Объявление Фото
Графский Парк Фото
Курт Кобейн Смерть Фото С Ружьем
Скачать Фото Из Инстаграм В Хорошем Качестве
Картинки С Надписью Удален
Актеры Фильма Полцарства За Любовь Фото
Фото Ядерных Грибов
Порно Фото Зрелых Волосатых Баб
Роза Аляска Фото И Описание Отзывы
Темно Коричневый Цвет Фото
Калина Желтая Фото
Английский Шпиц Фото
Парк Ривьера Сочи Цена 2022 Фото
Заморские Овощи Фото С Названиями
Фото На Памятник Ярославль Цена
Люди Цветы Картинки
Фото Марии Горбань Свежие
Скачать Программу Корректировки Фотографий
Разуменко Лилия Витальевна Фото
Картинки Секс Бесплатные С Медсестрами
Онлайн Картинки Красивые Цветы
С Первым Днем Сессии Картинки Прикольные
Интерьер Спальни Небольшой Комнаты Фото
Мусоргский Картинки С Выставки Слушать
Фото Брюнеток С Челкой
Картинки День Любленных
Лотте Отель Москва Фото
Салат Тигр Фото
Фото Зубов Мейн Куна
Сырный Соус Рецепт Пошаговый С Фото
Красные Картинки С Надписями
Крем Велюр Для Торта Рецепт С Фото
Виды Лошадей Фото И Описание И Название
Фото Вставить В Зимний Костюм
Член Фото Парни Кончают
Скачать Картинки Для Презентации Для Детского Сада
Группа Раком Фото


















/imgs/2021/03/07/06/4548289/4c10cdde0417b30884d2e579c6f94697bd56365d.jpg)










_(1)_d_850.jpg)

q94/-jnttpTCT7uYYLFMpnBLVA">

/imgs/2021/11/19/19/5039478/25bc4c93156adcb3c91e792f57c7823ebc535a35.jpeg)












/imgs/2021/06/10/11/4711473/81d1268798ce42a37f0cde5d318fe0d55c732acc.jpg)
















